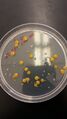

Search for duplicate files
From OpenWetWare
Jump to navigationJump to search
Search for duplicate files based on hash values.
2,988 × 5,312 pixel
File size: 3.35 MB
MIME type: image/jpeg
The file "10^-3_with_TET.jpg" has no identical duplication.
- 10^-3 with TET.jpg . . Allen D. Irving (talk | contribs) . . 04:25, 4 February 2016